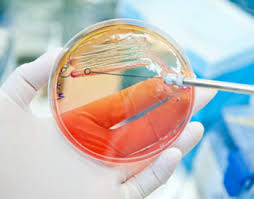
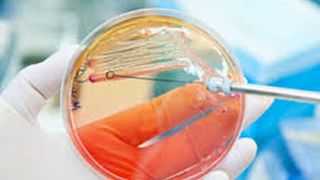

Controalele facute de inspectorii Autoritatii Nationale Sanitar-Veterinare (ANSVSA) in perioada 16 mai - 30 decembrie 2016 au dus la descoperirea bacteriei Escherichia Coli (E.Coli) in 69 de probe din lapte, cascaval, mici, carne de oaie, carne de vita, carnati, pastrama, si hamburgeri, la nivelul intregii tari.
ANSVSA anunta ca, potrivit raportului Institutului de Igiena si Sanatate Publica Veterinara, in perioada 16 mai- 30 decembrie 2016 in cadrul Planului National de Control pentru determinarea prevalentei Escherichia Coli verotoxigena in produse alimentare de origine animala au fost prelevate si analizate un numar de 1.484 probe de lapte, branza, cascaval, carne, mici, carnati, snitele si hamburgeri.
Probele au fost recoltate din: abatoare, magazine alimentare, carmangerii, supermarketuri si dozatoare de lapte, din Bucuresti si toate judetele tarii.
Buletinele de analiza au confirmat prezenta E.coli in 69 de probe prelevate din:
- lapte crud de bovina, de la o ferma din judetul Alba si de la o alta din Prahova
- carcasa de ovina, de la patru abatoare din Maramures, unul din Calarasi, trei din Buzau, sase din Timis, sase din Sibiu, trei din Bistrita-Nasaud, patru din Valcea, unul din Suceava;
- mici vita oaie, de la un hypermarket din judetul Teleorman;
- carnati Plescoi uscati Valmar, judetul Mures;
- pasta de mici, hypermarket, judet Gorj;
- pasta de mici vita/oaie, supermarket, judet Caras-Severin;
- pastrama din piept de oaie, hipermarket, judet Brasov;
- carne de vita, macelarie, Bucuresti;
- pasta de mici vita/porc, carmangerie, judet Bucuresti;
- branza de vaci, centru prelucrare lapte integrat, judet Ialomita;
- carne tocata vita, magazin alimentar, judet Tulcea;
- carnati amestec subtiri, magazin alimentar, judet Tulcea;
- pasta de mici speciala, restaurant, judet Caras Severin;
- telemea oaie, judet Olt;
- mici vita/oaie, restaurant, judet Giurgiu;
- cas proaspat, centru prelucrare lapte, judet Vaslui;
- carne tocata vita, carmangerie, judet Iasi;
- carnati vita/oaie, supermarket, judet Dambovita;
- lapte crud de vaca, ferma, judet Dolj;
- mici vita/porc, carmangerie, judet Maramures;
- carne tocata de vita, supermarket, judet Gorj;
- carne porc, vita, supermarket, judet Valcea;
- pasta de mici refrigerata, carmangerie, judet Teleorman;
- mici porc/vita, supermarket, judet Tulcea;
- pasta de mici, carmangerie, Bucuresti;
- hamburger, supermarket, judet Gorj;
- pasta de mici vita/oaie, supermarket, judet Iasi;
- carne tocata vita, supermarket, judet Timis.
Sursa: News.ro